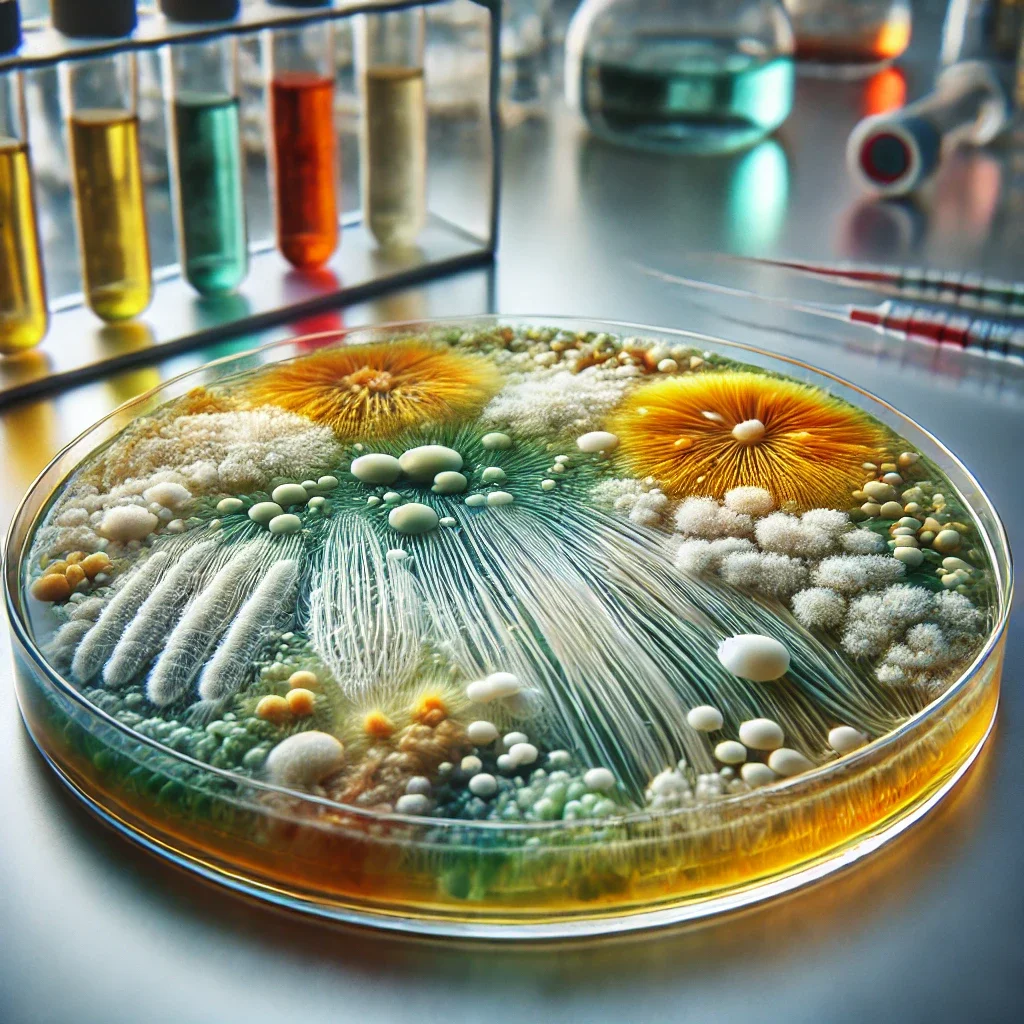

Core capability areas
The Phalanx Group is a veteran-owned CBRNe consulting, training, and capability development organization specializing in operationally grounded solutions for military, first responders, and critical infrastructure partners. Phalanx integrates real-world operator experience with technical expertise to deliver training, advisory, and product-support services that are realistic, defensible, and fieldable.
Phalanx operates at the intersection of operations, training, and technology, supporting clients across preparedness, response, and capability modernization efforts.
-
Phalanx delivers instructor-led and scenario-based CBRNe training aligned with national standards and real-world operational requirements.
Training Domains Include:
CBRNe Awareness, Operations, and Technician-level instruction
Detection & Monitoring Fundamentals
PPE & Respiratory Protection
Decontamination Principles
CBRNe Decision-Making for Leaders
Scenario-Based Tabletop and Functional Exercises
Training is designed for adult learners and emphasizes decision-making, threat prioritization, and operational risk management.
-
Phalanx provides advisory support to organizations seeking to strengthen preparedness, response capability, and program effectiveness.
Consulting Services Include:
SOP and policy development
Program and capability gap analysis
Equipment modernization guidance
Grant and funding support (SBIR/STTR, preparedness grants)
Exercise design and evaluation support
-
Phalanx provides operator-driven product evaluation, refinement, and capability integration services for emerging CBRNe/EOD technologies. This service line bridges the gap between engineering design and real-world operational adoption, ensuring products align with user workflows, evaluation criteria, and acquisition pathways.
This capability supports:
SBIR / STTR Phase I–III programs
OTA and BAA submissions
Prototype demonstrations and pilot deployments
Product redesigns following unsuccessful bids or limited market adoption
Operator-Centered Product Evaluation
Structured evaluations conducted from the perspective of end-users operating in PPE-restricted, time-compressed environments.
Evaluation Focus Areas:
Human factors (dexterity, visibility, fatigue, don/doff, heat burden)
Workflow integration (detection → decision → action)
Sustainment realities (battery life, maintenance, training burden)
False alarm management and decision confidence
Compatibility with PPE, respiratory protection, and decontamination procedures
Deliverables Include:
Operator usability assessments
Operational risk registers
Adopt / Modify / Reject recommendations
Early failure-mode identification
Requirements Translation & Capability Alignment
Phalanx translates operator needs and mission constraints into measurable, acquisition-relevant requirements.
Services Include:
CONOPS and mission-thread development
Measures of Effectiveness (MOE) and Measures of Suitability (MOS)
Requirements traceability matrices
Alignment with military, federal, and civilian response doctrine
Identification of appropriate end-user markets
Product Improvement & Redesign Support
Phalanx supports iterative redesign by identifying barriers to adoption that commonly prevent successful fielding.
Common Drivers Identified:
Cognitive overload in PPE
Inadequate indication of system degradation or failure
Excessive training burden relative to operational benefit
Logistics and sustainment friction
Misalignment with operational decision authority
Outputs Include:
Prioritized redesign recommendations
Operator-validated feature requirements
Integration guidance for accessories, adapters, or modular systems
Test Design & Evaluation Planning
Phalanx develops defense-ready test plans aligned with realistic evaluation practices.
Includes:
Scenario-based operational testing
Bench-to-field transition testing
Human-in-the-loop evaluations
Data collection frameworks suitable for proposals and technical reports
Risk-informed test matrices aligned with CBRNe threat profiles
Proposal & Capture Support (Non-Competing)
Phalanx strengthens operator relevance within industry proposals without competing for prime contracts.
Support Includes:
Operator-focused technical narratives
Prototype and subsystem integration language
Evaluation and validation sections
Transition-to-fielding strategies
Identification of operational stakeholders and adopters
-
CBRN respiratory protection and filtration systems
Chemical, radiological, and particulate detection technologies
Decontamination systems and consumables
Bio sampling, screening, and field identification workflows
CBRNe decision-support and situational awareness tools
Operator accessories, adapters, and system integrations
-
Led by career CBRNe, Medical, and EOD operators and instructors
Extensive experience in PPE-restricted and high-risk environments
Deep understanding of evaluation and acquisition pathways
Trusted by industry peers and government stakeholders
Focused on adoption, survivability, and transition—not just performance
Phalanx does not simply validate products — we make them usable, defensible, and fieldable.
-
Fire and HAZMAT teams
Law enforcement and special response units (Bomb Squad, SWAT, HAZMAT)
Emergency management agencies
Industrial safety and response teams
Government and private organizations with CBRNe risk (MEDICAL, CBRN, EOD)
-
These services position The Phalanx Group as a full-spectrum CBRNE capability partner, not a single-lane training vendor or advisory firm. By operating at the intersection of operator experience, technical evaluation, and acquisition awareness, Phalanx is able to support capabilities from concept through operational adoption.
Unlike organizations that focus solely on instruction, policy, or engineering, Phalanx integrates training, consulting, and product evaluation into a unified approach. This allows emerging technologies and programs to be assessed against real operational workflows, refined before costly acquisition failures, and aligned with how CBRNe/EOD threats are actually detected, managed, and mitigated in the field.
The result is faster capability maturation, reduced risk during evaluation, and solutions that are not only compliant, but usable, defensible, and trusted by operators.
